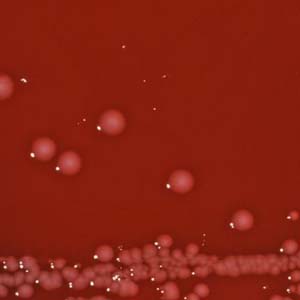
Shigella
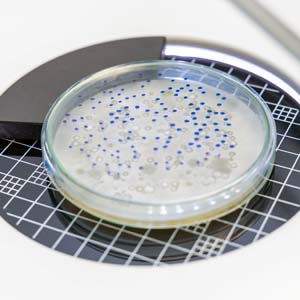
Totalbacterialcount(TBC)
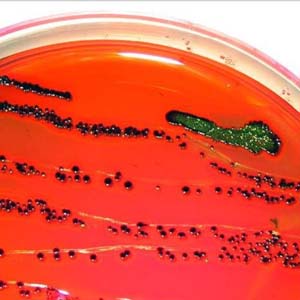
Coliformbacteria
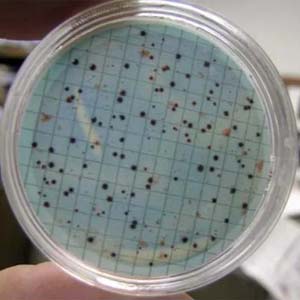
Enumerationoffecalcoliforms
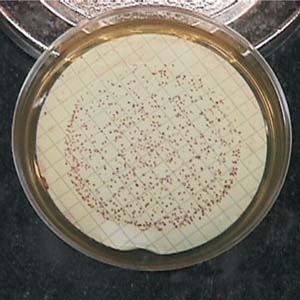
FecalStreptococcus
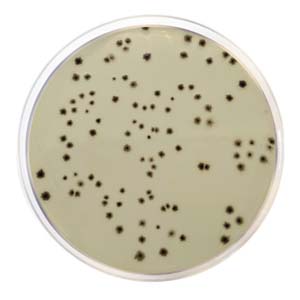
Anaerobicsulfite-reducingClostridia
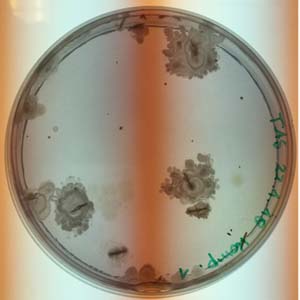
Thermophilicaerobicbacterialspores
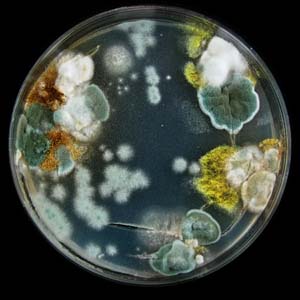
Enumerationofmolds
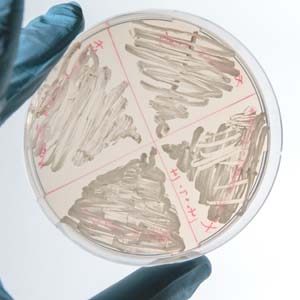
Enumerationofyeast
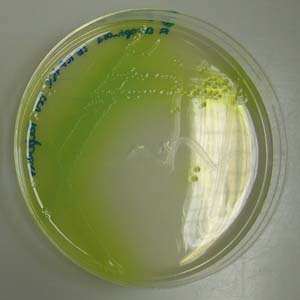
Pseudomonasaeruginosa
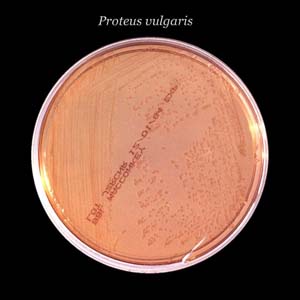
Proteusbacillus

Microbiological Test Service
The Role of Microbiological Testing in Food Quality Assurance
Microbiological contamination in food is a significant public health concern due to the presence of various nutrients in food that can support the growth and proliferation of microorganisms. These contaminants can include bacteria, viruses, fungi, and parasites, which can lead to foodborne illnesses and pose serious threats to human health. To mitigate these risks, microbiological testing has emerged as a crucial component in the food production and quality assurance process.
Microbiological testing is essential for ensuring the safety and quality of food products. It helps identify and quantify the presence of microorganisms, thereby allowing food manufacturers to implement appropriate measures to control contamination. This testing process is vital for maintaining consumer confidence and preventing outbreaks of foodborne diseases.

At Creative BioMart , we offer comprehensive Microbiological Testing Services supported by state-of-the-art equipment, high-biosafety laboratories, and strict sterile techniques. With extensive experience across food, agricultural products, cosmetics, and environmental samples, we ensure fast, accurate, and reproducible results. All testing is conducted with high sensitivity and full compliance with international standards.
Explore Our Microbiological Test Service
Service Procedure

What We Test
|
Item |
Details |
|---|---|
|
Total Bacterial Count |
Measures the total colony-forming units (CFU) per gram, milliliter, or surface area under controlled culture conditions. Indicates overall microbial load. |
|
Coliform Count |
Detects coliform bacteria including Escherichia coli , Citrobacter , Enterobacter , and Klebsiella , often used as indicators of fecal contamination. |
|
Pathogen Detection |
Includes critical foodborne pathogens such as Salmonella , Shigella , Staphylococcus aureus , and pathogenic Streptococcus , which are strictly prohibited in food products. |
|
Parasite Identification |
Detection of parasitic contamination in raw and ready-to-eat foods. |
|
Product-Specific Testing |
|
Microbiological Test Items
Critical Pathogens & Food Safety Indicators
-

Salmonella
-

Listeria monocytogenes
-

Escherichia coli O157:H7
-

Diarrheogenic E. coli
-

Staphylococcus aureus
-
Shigella
-

Campylobacter jejuni
-

Clostridium perfringens
-

Bacillus cereus
-

Vibrio parahaemolyticus
-

Vibrio cholera
-

Enterobacter sakazakii
Indicator Organisms (Fecal and Hygiene Indicators)
-
Total bacterial count (TBC)
-
Coliform bacteria
-
Enumeration of fecal coliforms
-

Enterobacteriaceae family
-
Fecal Streptococcus
-
Anaerobic sulfite-reducing Clostridia
Spores & Heat-Resistant Organisms
-
Thermophilic aerobic bacterial spores
-

Flat-sour spores
-

Desulfotomaculum nigrificans
-

Thermoanaerobacterium thermosaccharolyticum
Spoilage & Functional Bacteria
-
Enumeration of molds
-
Enumeration of yeast
-

Psychrotrophic microorganisms
-
Pseudomonas aeruginosa
-

Lactobacillus acidophilus
-

Lactobacillus bulgaricus
-

Bifidobacterium
-
Proteus bacillus
Other Bacteria
-

Staphylococcus haemolyticus
-

Streptococcus thermophilus
-

Fecal Streptococcus
Non-Bacterial Items
-

Mite
-

Commercial sterilization
Applications
- Raw materials and processed foods
- Functional foods and dietary supplements
- Traditional Chinese medicine and herbal products
- Cosmetics and personal care items
- Environmental hygiene indicators (air, surfaces, water)
Advantages of Our Microbiological Testing Service
- Advanced Instrumentation : High-biosafety level equipment and validated microbial platforms ensure high sensitivity and consistent performance.
- Fast Turnaround Time : Standard and expedited testing options available to meet your production timelines.
- International Standards Compliance : All tests are performed in accordance with global food safety standards (e.g., ISO, FDA, EU, GB).
- Cross-Industry Applications : Microbiological testing services available for food, agricultural products, cosmetics, and environmental samples.
- Customizable Testing Panels : Tailored test plans based on product type, risk assessment, and destination market requirements.
- Expert Technical Support: Our experienced microbiologists provide end-to-end guidance from sampling strategies to interpreting results.
Case Studies on Detection of Bacteria in Food
* NOTE: We prioritize confidentiality to safeguard our clients’ technology and intellectual property. As an alternative, we present selected published research articles as representative case studies. For details on the assay services and products used in these studies, please refer to the relevant sections of the cited literature.
Case 1: Clostridium perfringens in traditional salted sardine
Salama et al ., 2024. doi:10.21608/bvmj.2024.317434.1867
This study found that Clostridium perfringens , a toxin-producing and drug-resistant foodborne pathogen, was present in 20% of Egyptian salted fish samples, with the highest detection in Feseikh (30%). Many isolates showed multi-drug resistance, especially to clindamycin (72.2%), and carried key virulence ( plc , proA , cpe ) and resistance ( bla , ermB ) genes. The results highlight a potential health risk from consuming traditional salted fish products in Egypt, due to the presence of toxigenic, antibiotic-resistant C. perfringens .
Figure 1. Incidence of Clostridium perfringens in the examined salted fish samples (n=30). *. incidence (%) in relation to number of each fish product (30). **: incidence (%) in relation to the total number of the examined fish samples (90). (Salama et al. , 2024)
Case 2: Salmonella , Staphylococcus , and Proteus on eggs
Mehmood et al ., 2024. doi:10.22271/veterinary.2024.v9.i3g.1465
A study in Punjab, Pakistan, assessed bacterial contamination risks in 360 eggs categorized as clean, soiled, and unclean. Pathogens including Salmonella , Proteus , and Staphylococcus were most prevalent in unclean eggs. All isolates were sensitive to Ofloxacin and Cefotaxime, with some also responding to Trimethoprim + Sulphamethoxazole. The findings highlight the importance of eggshell hygiene and support strategies to reduce contamination and improve egg safety, addressing global concerns about foodborne illnesses.
Figure 2. Percentage prevalence bacterial isolates in unclean eggs. (Mehmood et al ., 2024)
Client Experiences with Our Food Microbiology Testing Services
"Creative BioMart provided a comprehensive microbiological assessment for our probiotic product line, including enumeration of Lactobacillus acidophilus and Bifidobacterium . Their precision and documentation helped us meet EU regulatory requirements without delay."
— Director of R&D | Nutritional Supplement Manufacturer
"Our team worked with Creative BioMart to test environmental swabs for total bacterial count and coliforms across our cleanroom facility. Their sampling guidance and ISO-compliant protocols were top-notch, helping us tighten our hygiene monitoring program effectively."
— Senior Microbiologist | Pharmaceutical Manufacturing Plant
"We approached Creative BioMart for comprehensive testing of seafood products, including Vibrio parahaemolyticus , Salmonella , and total yeast count. Their staff was highly specialized and delivered results that aligned perfectly with Japanese import standards. We’ll definitely use their services again."
— Regulatory Affairs Specialist | International Seafood Processor
"Creative BioMart helped us validate a new cosmetic product with microbial tests including Pseudomonas aeruginosa and enumeration of molds and yeasts. The clarity of their reports and responsiveness to technical queries were beyond expectations. An excellent partner for high-stakes product launches."
— Formulation Scientist | Personal Care & Beauty Brand
FAQs on Our Microbiological Testing Service
-
Q: What types of samples do you accept for microbiological testing?
A: We test a wide range of sample types, including food products, raw ingredients, agricultural goods, cosmetics, environmental swabs, and healthcare-related materials. -
Q: How fast can I get my results?
A: Our standard turnaround is 5–7 business days, but we also offer priority service (48–72 hours) for time-sensitive projects or regulatory deadlines. -
Q: Do your tests comply with international standards?
A: Yes. All tests are performed according to ISO, FDA, GB, and Codex standards, ensuring full compliance with global food safety and healthcare regulations. -
Q: What microbial indicators or pathogens can you detect?
A: We provide testing for a full spectrum of microbes including:- Salmonella , Listeria monocytogenes , E. coli , Staphylococcus aureus , Vibrio spp. , Clostridium perfringens
- Total bacterial count, coliforms, molds, yeasts, and spore-formers
- Probiotics like Lactobacillus and Bifidobacterium
-
Q: How do you ensure the accuracy and reliability of results?
A: All tests are conducted in biosafety-level laboratories using validated methods, sterile techniques, and rigorous quality control, including internal standards and control samples in every run. -
Q: Do you offer customized testing plans?
A: Yes. We tailor microbiological test panels based on product type, target market, and risk profile, ensuring efficient, relevant, and cost-effective analysis.
Resources
Related Services
Related Products
References:
- Gerba CP, Pepper IL. Chapter 17 - Microbial Contaminants, eds. Environmental Monitoring and Characterization . Elsevier Academic Press; 2004. doi:10.1016/B978-012064477-3/50019-9.
- Giambra IJ, Jahan Y, Yin T, Engel P, Weimann C, Brügemann K, König S. Identification of Thermophilic Aerobic Sporeformers in Bedding Material of Compost-Bedded Dairy Cows Using Microbial and Molecular Methods. Animals . 2021; 11(10):2890. doi:10.3390/ani11102890
- Mehmood MD, Ul-Haq HA, Saba N, Habib R, Ghani MU. Microbiological analysis: Prevalence of salmonella, staphylococcus, and proteus on the surface of table and hatchable eggs, along with their antibiotic sensitivity profile. Int J Vet Sci Anim Husbandry . 2024;9(3):495-502. doi:10.22271/veterinary.2024.v9.i3g.1465
- O’Driscoll, N.H., Cushnie, T.P.T., Matthews, K.H. et al. Colistin causes profound morphological alteration but minimal cytoplasmic membrane perforation in populations of Escherichia coli and Pseudomonas aeruginosa. Arch Microbiol 200, 793–802 (2018). https://doi.org/10.1007/s00203-018-1485-3
- Salama TO, Abd El-Tawab AA, Nabil M. Incidence, antibiotic resistance, and virulence profile of Clostridium perfringens in traditional salted sardine, Feseikh and Renga. Benha Veterinary Medical Journal . 2024;47(1):129-134. doi:10.21608/bvmj.2024.317434.1867
Contact us or send an email at for project quotations and more detailed information.
Quick Links
-
Papers’ PMID to Obtain Coupon
Submit Now -
Refer Friends & New Lab Start-up Promotions